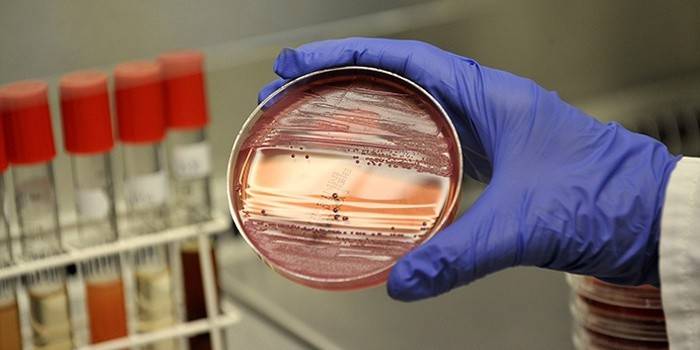

Rzeżączka u kobiet
Infekcje przenoszone drogą płciową - plaga nowoczesności. Często mężczyźni i kobiety lekkomyślnie odnoszą się do swoich partnerów, a potem gorzko żałują. Jak rzeżączka objawia się u kobiet? Objawy są subtelne, a zaawansowane stany są niezwykle trudne do leczenia. Dla płci pięknej choroba jest bardzo niebezpieczna. Powoduje wejście i rozprzestrzenianie się patogennych bakterii gonococcus w całym ciele. Choroba prowadzi do procesów zapalnych macicy, które powodują bezpłodność i złożone porody.
Objawy rzeżączki u kobiet
Brak objawów choroby przenoszonej drogą płciową nie jest rzadkością. Rozpoznanie przewlekłej rzeżączki następuje po 2 miesiącach od wejścia mikroorganizmu gonococcus do organizmu. Często choroba przechodzi w tę formę z powodu samoleczenia. Najpierw przyjrzyj się bliżej sobie, czy masz jakieś objawy rzeżączki u kobiet (patrz zdjęcie):

- Ból, swędzenie, pieczenie w narządach płciowych, w pochwie.
- Nieprzyjemny zapachmający ropne, żółte, zielonkawe odcienie.
- Ból podczas stosunku i oddawania moczu.
- Rysowanie bólów w pachwinie, dolnej części pleców, niezwiązanych z miesiączką.
Pierwsze znaki
Jeśli choroba jest ostra, łatwiej będzie ci poradzić sobie z problemem. Ten stan choroby leczy się skuteczniej i szybciej, a bakterie gonococcus nie mają czasu, aby spowodować nieodwracalne zmiany w ciele. Oznaki ostrej rzeżączki wyrażają się klasycznymi objawami, często w postaci zapalenie jamy ustnej, zapalenie spojówek, zapalenie węzłów chłonnych, gorączka.
Leki na rzeżączkę
Czynnik sprawczy choroby jest niezwykle adaptacyjny do leków, dlatego w leczeniu stosuje się złożoną terapię. Jak leczyć rzeżączkę u kobiet? Połączenie leków i schematu dawkowania określa lekarz zgodnie z wynikami wysiewu. Rzeżączka u kobiet jest leczona głównie tabletkami, a podczas ciąży przechodzą na czopki. Wszystkie leki są antybiotykami o szerokim spektrum interakcji i są podzielone na:
- chloramfenikol;
- tetracyklina;
- makrolidy;
- aminoglikozydy i inne.
Diagnoza choroby
Jeśli znajdziesz oznaki infekcji, natychmiast skontaktuj się z ginekologiem. Konieczne jest zdiagnozowanie choroby we wczesnych stadiach. Pozwoli to lekarzowi przepisać ci skuteczne leczenie. Diagnozę przeprowadza się w laboratorium metodą bakteriologiczną - rozmaz na rzeżączkę. Wynik określa obecność patogenu w mikroflorze żeńskiej.

Nie zawsze jest możliwe ustalenie przewlekłych postaci choroby za pomocą rozmazu. Następnie zastosuj metodę reakcji łańcuchowej polimerazy. Dokładność analizy wynosi 99%. Zaletą tej metody jest to, że obecność nie tylko rzeżączki, ale także innych chorób przenoszonych drogą płciową, na przykład chlamydii, zależy od jednego ogrodzenia. Brak PCR wiąże się z wysokimi kosztami, co nie zawsze jest uzasadnione.
Jak pobiera się rozmaz rzeżączkę?
Zasady gromadzenia danych są proste:
- Nie wykonuj procedury podczas menstruacji!
- Przed przyjęciem ginekologa nie oddawaj moczu przez 2 godziny.
- Z pochwy i cewki moczowej pobierany jest rozmaz.
- Skrobanie nakłada się na szkło przekazane do laboratorium.
- Odszyfrowanie analizy jest dostarczane pacjentowi.

Jakie testy wziąć
Jeśli badanie rozmazu na rzeżączkę dało wynik pozytywny, niektóre ogólne testy są zalecane jako dodatek. Na podstawie ich wyników ocenia się przystępne cenowo sposoby walki o zdrowie. Lekarz wykryje chorobę (np. cukrzyca, niedokrwienie), z powodu którego niektóre leki są przeciwwskazane do stosowania. W oparciu o połączenie wyników rozmazu i ogólnych analiz opracowano złożoną terapię:
- badanie krwi powie o intensywności przebiegu procesów zapalnych w ciele;
- biochemia krwi odzwierciedla stan pracy narządów wewnętrznych, obecność chorób przewlekłych;
- cytologia moczu i biochemia pokazują, jak daleko zaszły procesy zapalne, jak bardzo wpłynęły na układ moczowo-płciowy i pokrewne.
Skutki rzeżączki
Terminowe wyleczenie jest bardzo ważne - problem grozi rozwinięciem się w takie problemy, jak:
- Niepłodność spowodowana zapaleniem narządów miednicy.
- Ropień jajowodów, który rozprzestrzenia się na macicę i jajniki.
- Bolesny seks z powodu zapalenia warg sromowych warg głównych.
- Wysokie ryzyko ciąży pozamacicznej.
- Zapalenie okołow wątrobowe, zrosty
- U kobiet w ciąży istnieje ryzyko poronienia. Jeśli dziecko rodzi się naturalnie, prawdopodobieństwo zarażenia rzeżączki od matki wynosi 100%.
Wideo: co to jest rzeżączka
Okres inkubacji choroby przenoszonej drogą płciową trwa od 3 do 5 dni, czasami wynosi 2 lub więcej tygodni. Po przyjeździe objawy rzeżączki. Jeśli podejrzewasz infekcję, wykonaj testy. Lekarz przepisuje leczenie antybiotykami, kurs trwa 1-2 dni dla ostrych postaci i 5-7 dla przewlekłych. Dowiedz się z filmu, dlaczego Bicillin 5. jest uważany za skuteczny lek na rzeżączkę. Zrozumiesz, dlaczego podczas leczenia pacjent jest monitorowany, jak jego ciało reaguje na stosowanie leku. Jeśli nie ma pozytywnego wyniku, antybiotyk się zmienia.
Jak to się manifestuje
Rzeżączka - definicja, przyczyny, sposoby zakażenia, okres inkubacji